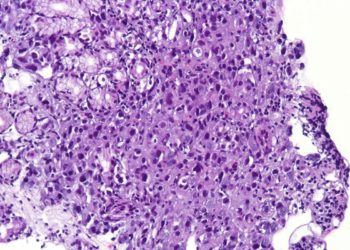

1. In patients with confirmed SARS-CoV-2 infection within 7 days before or 30 days after surgery, significant mortality was observed, and perioperative pulmonary complications occurred in more than half the patients.
Evidence Rating: 2 (Good)
Current guidelines regarding the management of surgical patients during the SARS-CoV-2 pandemic are based solely on expert opinion rather than systematic investigation. With spread to the majority of countries worldwide and significant burden in North America, the impact of the pandemic on postoperative recovery and outcomes must be meaningfully sorted out to better inform clinical decision making in these unprecedented times. To address this knowledge gap, investigators performed an international multicentre cohort study with 1128 surgical patients at 235 hospitals in 24 different countries. Of the 1128 patients included, 835 had received emergency surgery and 280 had received elective surgery. Positive infection was identified preoperatively in 294 patients and postoperatively in 806, either by quantitative RT-PCR or a combination of radiological and clinical findings. Primary outcome was 30-day postoperative mortality, and the secondary outcome measure of interest was pulmonary complications, consisting of pneumonia, ARDS, or unexpected postoperative ventilation. Thirty day mortality rates were observed to be 23.8%, much higher than the pre-established baseline of 3% from prior investigations. A significant portion of these deaths were due to pulmonary complications (82.6%), which were present in 51.2% of SARS-CoV-2 positive patients. Again, this is much higher than the 10% that has previously been identified as the baseline rate of perioperative pulmonary complications. In adjusted analyses, male sex (odds ratio 1·75 [95% CI 1·28–2·40], p<0·0001), age 70 years or older versus younger than 70 years (2·30 [1·65–3·22], p<0·0001), concurrent morbidities (as identified as American Society of Anesthesiologists grades 3–5 versus grades 1–2) (2·35 [1·57–3·53], p<0·0001), malignant versus benign or obstetric diagnosis (1·55 [1·01–2·39], p=0·046), emergency versus elective surgery (1·67 [1·06–2·63], p=0·026), and major versus minor surgery (1·52 [1·01–2·31], p=0·047) were identified as factors associated with 30-day mortality. Although not all patients were identified as SARS-CoV-2 positive via laboratory investigation, study findings strongly suggest that perioperative infection with SARS-CoV-2 is associated with high rates of mortality and pulmonary complications relative to pre-established observations. As such, clinicians are advised by investigators to have a higher threshold for surgical intervention, and take additional measures in preventing infection in preventing infection in surgical patients if possible.
Click to read the study in Lancet
©2020 2 Minute Medicine, Inc. All rights reserved. No works may be reproduced without expressed written consent from 2 Minute Medicine, Inc. Inquire about licensing here. No article should be construed as medical advice and is not intended as such by the authors or by 2 Minute Medicine, Inc.